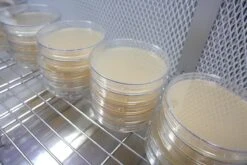
Gardena Verkoopwinkel 42 Gardena Verkoopwinkel -Gardena Verkoopwinkel 1200x800 49

Houd je tuinslang stevig op zijn plek – nu met een geweldige aanbieding!
Zorg voor een nette en efficiënte tuinslanginstallatie met deze set van 100 stevige grondpennen. Perfect voor het vastzetten van je tuinslang of druppelslang, zodat je waterleiding altijd stabiel en veilig blijft liggen.
Bewateringssystemen voor elke tuin
100 Plantenstekers Plantenetiketten Plantenlabels Wit
Houd je planten perfect georganiseerd met deze set van 100 witte plantenstekers en etiketten. Ideaal voor het labelen van je kruiden, bloemen en groenten, zodat je altijd precies weet wat waar staat!
Topkwaliteit Bemesting voor een Gezonde Tuin
Dcm Groen-Kalk 250 M2 – Kalk – 2 X 20 Kg (K)
Verbeter je bodem en boost je tuin met deze speciale aanbieding!
Geef je tuin de beste verzorging met Dcm Groen-Kalk, ideaal voor het neutraliseren van zure bodems en het verbeteren van de bodemstructuur. Met deze voordelige verpakking van 2 zakken van 20 kg ben je klaar voor een optimale verzorging van maar liefst 250 m².